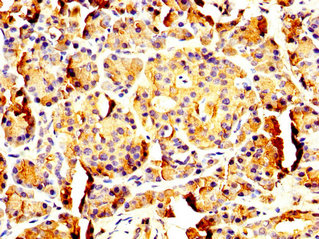

PNLIP Antibody
-
中文名稱:PNLIP兔多克隆抗體
-
貨號:CSB-PA018262LA01HU
-
規格:¥440
-
圖片:
-
IHC image of CSB-PA018262LA01HU diluted at 1:200 and staining in paraffin-embedded human pancreatic tissue performed on a Leica BondTM system. After dewaxing and hydration, antigen retrieval was mediated by high pressure in a citrate buffer (pH 6.0). Section was blocked with 10% normal goat serum 30min at RT. Then primary antibody (1% BSA) was incubated at 4°C overnight. The primary is detected by a biotinylated secondary antibody and visualized using an HRP conjugated SP system.
-
-
其他:
產品詳情
-
產品名稱:Rabbit anti-Homo sapiens (Human) PNLIP Polyclonal antibody
-
Uniprot No.:
-
基因名:
-
別名:lipase, pancreatic antibody; LIPP_HUMAN antibody; Pancreatic lipase antibody; Pancreatic triacylglycerol lipase antibody; PL antibody; PNLIP antibody; PNLIPD antibody; PTL antibody; Triacylglycerol acylhydrolase antibody
-
宿主:Rabbit
-
反應種屬:Human
-
免疫原:Recombinant Human Pancreatic triacylglycerol lipase protein (60-214AA)
-
免疫原種屬:Homo sapiens (Human)
-
標記方式:Non-conjugated
本頁面中的產品,PNLIP Antibody (CSB-PA018262LA01HU),的標記方式是Non-conjugated。對于PNLIP Antibody,我們還提供其他標記。見下表:
-
克隆類型:Polyclonal
-
抗體亞型:IgG
-
純化方式:>95%, Protein G purified
-
濃度:It differs from different batches. Please contact us to confirm it.
-
保存緩沖液:Preservative: 0.03% Proclin 300
Constituents: 50% Glycerol, 0.01M PBS, pH 7.4 -
產品提供形式:Liquid
-
應用范圍:ELISA, IHC
-
推薦稀釋比:
Application Recommended Dilution IHC 1:200-1:500 -
Protocols:
-
儲存條件:Upon receipt, store at -20°C or -80°C. Avoid repeated freeze.
-
貨期:Basically, we can dispatch the products out in 1-3 working days after receiving your orders. Delivery time maybe differs from different purchasing way or location, please kindly consult your local distributors for specific delivery time.
-
用途:For Research Use Only. Not for use in diagnostic or therapeutic procedures.
相關產品
靶點詳情
-
功能:Plays an important role in fat metabolism. It preferentially splits the esters of long-chain fatty acids at positions 1 and 3, producing mainly 2-monoacylglycerol and free fatty acids, and shows considerably higher activity against insoluble emulsified substrates than against soluble ones.
-
基因功能參考文獻:
- Serum lipase subtype analysis cannot replace the standard lipase measurement for the diagnosis of acute pancreatitis, but the test demonstrated adequate sensitivity for use in triage or as an add-on test for serum lipase elevation. PMID: 27243230
- Presence of methionine at position 221 in the PNLIP protein sequence causes protein misfolding and aggregation. PMID: 25862608
- All these findings support the use of YLLIP2 in enzyme replacement therapy for the treatment of pancreatic exocrine insufficiency, a pathological situation in which an acidification of intestinal contents occurs. PMID: 24650780
- In patients with intraductal papillary mucinous neoplasm without a history of pancreatitis, serum pancreatic lipase and amylase outside normal range are associated with risk of malignancy. PMID: 25239347
- a novel mutation in the PNLIP gene in two brothers with congenital pancreatic lipase deficiency PMID: 24262094
- Low PNLIP expression is associated with pancreatic cancer. PMID: 23918603
- Triacylglycerol lipase and alpha-amylase are highly over-expressed in pancreatic cyst fluids in patients with mucinous pancreatic neoplasms. PMID: 22393262
- Combination of two mutations with a promising one at the entrance of the catalytic cavity (K80E) negatively affected the lipase activity at neutral pH but not that at acidic pH. PMID: 20150178
- the amplitude of the lid opening measured in solution or in a frozen solution in the presence of amphiphiles PMID: 20136147
- Review. The structure and function of the pancreatic lipase C2 domains, based on the recent 3D structures and improved sequence alignments are reviewed. PMID: 12369922
- analysis of human pancreatic lipase from pancreatic juice (BCR693) and a recombinant form (BCR694) PMID: 12667003
- examination of tryptophan changes in pancreatic lipase PMID: 14580194
- a specific method of measuring classical pancreatic lipase in human serum PMID: 15316225
- analysis of a lid hydrophobicity pattern in pancreatic lipase PMID: 16179352
- pancreatic lipase-colipase interactions in the presence of bile salt micelles are mediated by Val-407 and Ile-408 of PL PMID: 16431912
- Electron paramagnetic resonance spectroscopy along with site-directed spin labeling was used to monitor the conformational changes in the human PL lid in solution to assess the effects of partners of the lipase, i.e. colipase and bile salts. PMID: 17269661
- Introducing a negative charge close to the catalytic histidine induced a shift of the pH optimum toward acidic values but strongly reduced the lipase activity. PMID: 18353248
- The disulfide bridge between the hinges of the lid kept the secondary structure of the lid intact, whereas the HPL was completely unfolded. PMID: 19113953
- Trp-107 and Trp-253 contribute to the change in steady state fluorescence that is triggered by mixed micelles of inhibitor and bile salt. PMID: 19346257
顯示更多
收起更多
-
相關疾病:Pancreatic lipase deficiency (PNLIPD)
-
亞細胞定位:Secreted.
-
蛋白家族:AB hydrolase superfamily, Lipase family
-
數據庫鏈接:
Most popular with customers
-
-
YWHAB Recombinant Monoclonal Antibody
Applications: ELISA, WB, IHC, IF, FC
Species Reactivity: Human, Mouse, Rat
-
Phospho-YAP1 (S127) Recombinant Monoclonal Antibody
Applications: ELISA, WB, IHC
Species Reactivity: Human
-
-
-
-
-